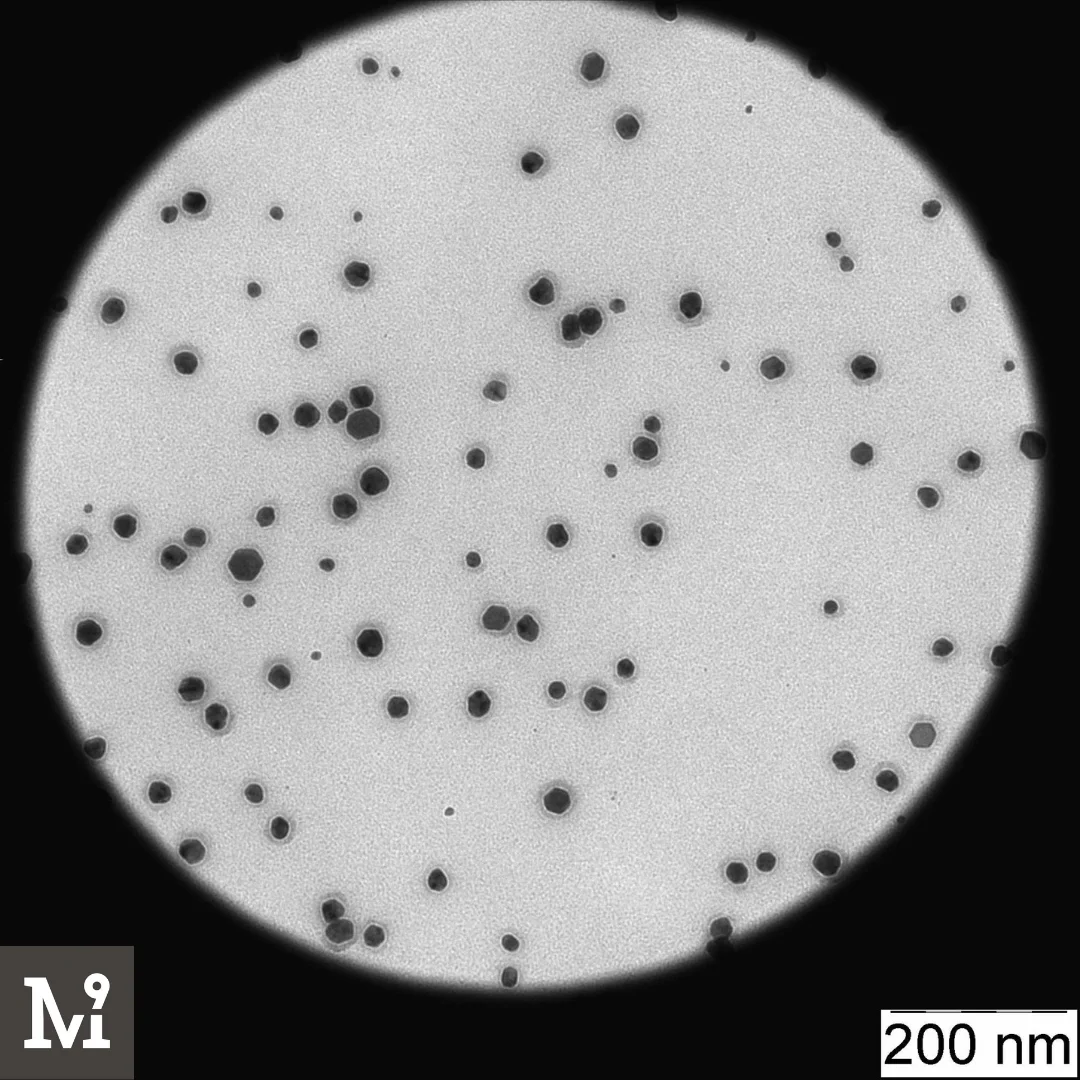

Хорошее качество наночастицы серебра AG Basic A 1000 ppm совместимы с анионными препаратами поливиол
- Категория: Elementary Substances >>>
- Поставщик: Ninetech LLC
Сохранить в закладки 11000001836494:
Описание и отзывы
Характеристики
Silver nanoparticles in colloidal solution - AG Basic A 1000
Properties:
Antibacterial, catalytic, optical, conductive
Scope of application: medicine, cosmetics, pharmaceuticals, catalysis, optics, electronics
Description:
Clear solution of high-quality silver nanoparticles, stabilized with a nonionic polymer (Polyviol). Soluble in water. It is used to develop cosmetic products, medical and pharmaceutical products. The solution is compatible with anionic formulations. It is stable over a broad pH range, resistant to free radicals. It can be used to create optical filters for the IR range and UV range.
Details:
- Particle size: 15 +- 8 nm
- Monodispersity: 65%
- Concentration: 1000 ppm
- Particle shape: spherical
- Solvent: water
- Stabilizer: Polyvinyl alcohol (5-88, 17-88, 24-88), 0,1 %
- PPR: 400 - 420 nm
- Stability pH: 6 - 10
- Solubility: water
- Thermal stability: 15 - 90 C
- Density: 1.01
- Stability: 12 months
- Storage conditions: +5 -+ 25 C

|  |

How to contact?
See contact section
Delivery methods
Express delivery or standard shipping
Payment methods
Bank transfer
Ninetech LLC
We are professionals in obtaining nanoparticles and creating innovative products. We embed nanoparticles into any material. We produce nanomaterials according to individual requirements for scientific research and experimental development. We provide all the characteristics and provide full technical support.
Похожие товары
Купить высокой чистоты сферической антибактериальный nano silver from hw nano материал
99.999% аргоновый газ цены на сварочный
20 нм Сферический Ag 99.99% высокочистый Сверхтонкий серебряный порошок наночастиц серебра
Очень Чистая Желтая гранулированная Сера промышленного класса от лучшего оптового
Оптовая продажа 6N 99.9999% водородный газовый цилиндр высокого давления резервуар заводские цены
Графеновые нанопластины, многослойный нанографеновый порошок
Серебристый 300-серебристый Наночастицы стабилизированный пантенолом купить напрямую от производителя запатентованный и сертифицированный
Новые поступления
Новинки товаров от производителей по оптовым ценам